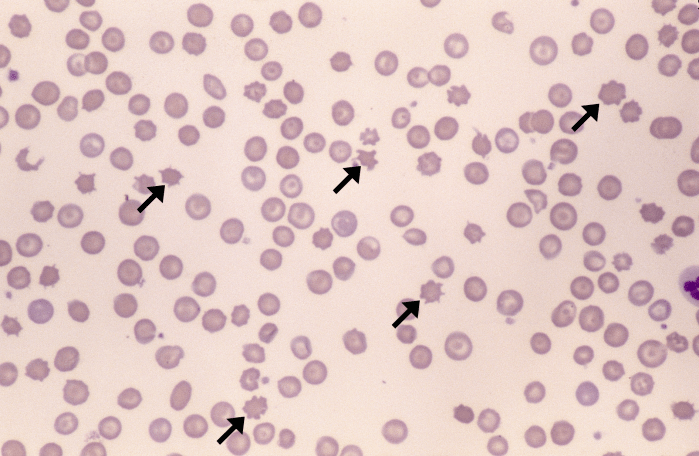
Acanthocytes 2 (Canine - HSA2) ARROWS
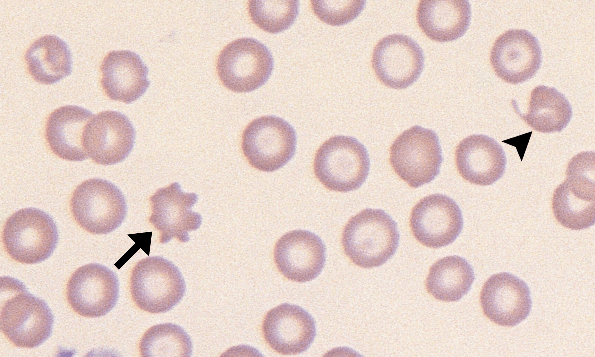
Acanthocytes 6 (Canine 3 - Iron Deficiency) ARROWS
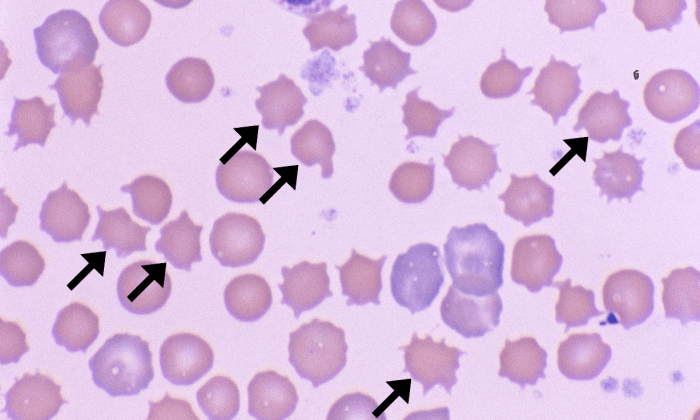
Acanthocytes 8 (Rabbit 1 - High Cholesterol Diet) ARROWS
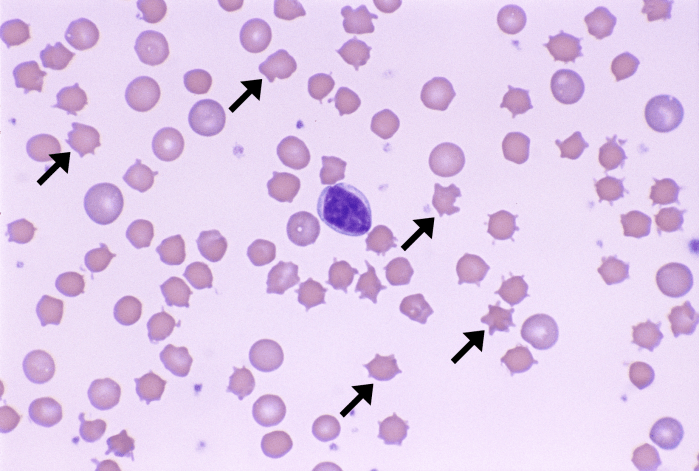
Acanthocytes 5 (Rabbit) ARROWS

Acanthocytes

Morphology: red blood cells with irregular spicules projecting from the cell surface. Spicules are variable in shape (blunt or bulbous tips), variable in size, and unevenly distributed around the periphery of the cell.
Look alike: echinocytes
Clinical relevance: may be associated with certain underlying disorders including hemangiosarcoma (dogs), liver disease (dogs and cats), disseminated intravascular coagulation (dogs), vasculitis (dogs), iron deficiency anemia (dogs). May also be observed in animals on high lipid diets. Small numbers may be normal in young ruminants (calves).